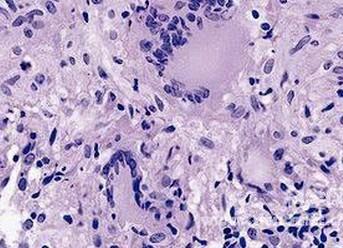

请问紫外线灯能杀死结核杆菌吗?要多少瓦.
请问紫外线灯能杀死结核杆菌吗?要多少瓦.
343x248 - 25KB - JPEG
 结核杆菌有什么特性?
结核杆菌有什么特性?
390x218 - 21KB - JPEG
 肺结核通过什么途径传染,肺结核怎么传染-
肺结核通过什么途径传染,肺结核怎么传染-
500x350 - 20KB - JPEG
 养猪场使用火碱消毒注意事项
养猪场使用火碱消毒注意事项
4320x3240 - 1305KB - JPEG
 养花有哪些好处:能增强人体免疫力,调理
养花有哪些好处:能增强人体免疫力,调理
550x402 - 145KB - JPEG
 请问紫外线灯能杀死结核杆菌吗?要多少瓦.
请问紫外线灯能杀死结核杆菌吗?要多少瓦.
300x225 - 77KB - JPEG
 吃烤蒜的功效与作用
吃烤蒜的功效与作用
500x330 - 25KB - JPEG
 请问紫外线灯能杀死结核杆菌吗?要多少瓦.
请问紫外线灯能杀死结核杆菌吗?要多少瓦.
500x331 - 84KB - JPEG
 请问紫外线灯能杀死结核杆菌吗?要多少瓦.
请问紫外线灯能杀死结核杆菌吗?要多少瓦.
640x430 - 68KB - JPEG
 研究发现增强谷氨酸激酶活性可杀死结核菌
研究发现增强谷氨酸激酶活性可杀死结核菌
529x321 - 99KB - JPEG
 结核分枝杆菌。人体内结核分枝杆菌的彩色
结核分枝杆菌。人体内结核分枝杆菌的彩色
1253x1280 - 214KB - JPEG

600x363 - 25KB - JPEG
 冻了的大蒜还能吃吗 看有无变质
冻了的大蒜还能吃吗 看有无变质
550x280 - 84KB - JPEG
结核菌对免疫细胞的反杀令科学家傻眼,
437x284 - 22KB - JPEG
 肺结核菌 怎样预防结核菌的传播
肺结核菌 怎样预防结核菌的传播
400x294 - 58KB - JPEG